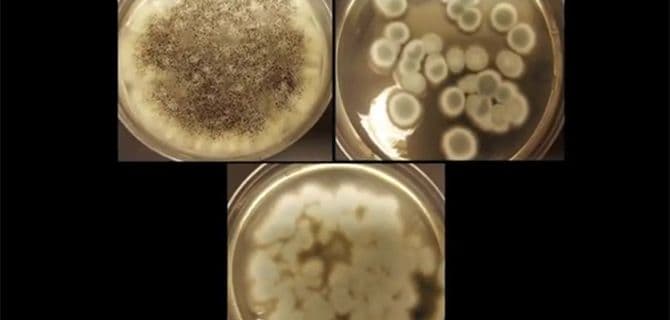

The rechargeable batteries in our smartphones, cars, and tablets can be charged again and again. But they don’t last forever. Old batteries often wind up in landfills or incinerators. These methods of disposal can be potentially harmful to the environment. At the same time, they also leave valuable materials behind in the discarded batteries. Now, […]
The rechargeable batteries in our smartphones, cars, and tablets can be charged again and again. But they don’t last forever. Old batteries often wind up in landfills or incinerators. These methods of disposal can be potentially harmful to the environment. At the same time, they also leave valuable materials behind in the discarded batteries.
Now, a team of researchers is turning to naturally occurring fungi to drive an environmentally friendly recycling process that extracts cobalt and lithium from tons of waste batteries. The fungi naturally produce acids that can leach metals from pulverized battery cathodes. Results so far show that using oxalic acid and citric acid, two of the organic acids generated by the fungi, up to 85% of the lithium and up to 48% of the cobalt were extracted from the cathodes of spent batteries. Unlike other methods for extracting these metals, this method doesn’t require large quantities of heat or harsh chemicals.
Watch Jeff Cunningham of the University of South Florida discuss this intriguing concept:
Get more great videos from the American Chemical Society.